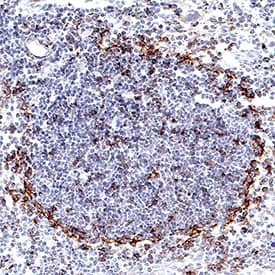
PD-L1/B7-H1 antibody in Mouse Thymus by Immunohistochemistry (IHC-Fr).

Mouse PD-L1/B7-H1 Antibody
R&D Systems, part of Bio-Techne | Catalog # MAB90781


Key Product Details
Validated by
Species Reactivity
Validated:
Cited:
Applications
Validated:
Cited:
Label
Antibody Source
Product Specifications
Immunogen
Met1-His239
Accession # Q9EP73
Specificity
Clonality
Host
Isotype
Scientific Data Images for Mouse PD-L1/B7-H1 Antibody
Detection of Mouse PD-L1/B7-H1 by Western Blot.
Western blot shows lysates of RAW 264.7 mouse monocyte/macrophage cell line and J774A.1 mouse reticulum cell sarcoma macrophage cell line untreated (-) or treated (+) with 10 µg/mL LPS for 4 hours. PVDF membrane was probed with 2 µg/mL of Rabbit Anti-Mouse PD-L1/B7-H1 Monoclonal Antibody (Catalog # MAB90781) followed by HRP-conjugated Anti-Rabbit IgG Secondary Antibody (Catalog # HAF008). A specific band was detected for PD-L1/B7-H1 at approximately 50-55 kDa (as indicated). This experiment was conducted under reducing conditions and using Immunoblot Buffer Group 1.Detection of PD-L1/B7-H1 in RAW 264.7 Mouse Cell Line by Flow Cytometry.
RAW 264.7 mouse monocyte/macrophage cell line either treated with LPS overnight (filled histogram) or untreated (open histogram) was stained with Rabbit Anti-Mouse PD-L1/B7-H1 Monoclonal Antibody (Catalog # MAB90781), followed by Allophycocyanin-conjugated Anti-Rabbit IgG Secondary Antibody (Catalog # F0111). View our protocol for Staining Membrane-associated Proteins.Detection of PD-L1/B7-H1 in HEK293 Human Cell Line Transfected with Mouse PD-L1/B7-H1 and eGFP by Flow Cytometry.
HEK293 human embryonic kidney cell line transfected with either (A) mouse PD-L1/B7-H1 or (B) irrelevant transfectants and eGFP was stained with Rabbit Anti-Mouse PD-L1/B7-H1 Monoclonal Antibody (Catalog # MAB90781) followed by Allophycocyanin-conjugated Anti-Rabbit IgG Secondary Antibody (Catalog # F0111). Quadrant markers were set based on control antibody staining (Catalog # MAB1050). View our protocol for Staining Membrane-associated Proteins.Applications for Mouse PD-L1/B7-H1 Antibody
Flow Cytometry
Sample: RAW 264.7 mouse monocyte/macrophage cell line treated with LPS and HEK293 human embryonic kidney cell line transfected with mouse B7-H1/PD-L1
Immunohistochemistry
Sample:
Perfusion fixed frozen sections of mouse thymus
Western Blot
Sample: RAW 264.7 mouse monocyte/macrophage cell line and J774A.1 mouse reticulum cell sarcoma macrophage cell line treated with LPS
Reviewed Applications
Read 10 reviews rated 4.4 using MAB90781 in the following applications:
Formulation, Preparation, and Storage
Purification
Reconstitution
Formulation
Shipping
Stability & Storage
- 12 months from date of receipt, -20 to -70 °C as supplied.
- 1 month, 2 to 8 °C under sterile conditions after reconstitution.
- 6 months, -20 to -70 °C under sterile conditions after reconstitution.
Background: PD-L1/B7-H1
Mouse B7 homolog 1(B7-H1), also called programmed death ligand 1 (PD-L1) and programmed cell death 1 ligand 1 (PDCD1L1), is a member of the B7 family of proteins that provide signals for regulating T-cell activation and tolerance (1-4). Other family members include B7-1, B7-2, B7-H2, B7-H3 and PD-L2. B7 proteins are immunoglobulin (Ig) superfamily members with extracellular Ig-V-like and Ig-C-like domains and a short cytoplasmic region. Among the family members, they share from 20-40% amino acid (aa) sequence identity. The cloned mouse B7-H1/PD-L1 cDNA encodes a 290 aa type I membrane precursor protein with a putative 18 aa signal peptide, a 220 aa extracellular region containing one V-like and one C-like Ig domain, a 22 aa transmembrane region, and a 30 aa cytoplasmic domain. Mouse and human B7-H1/PD-L1 share approximately 70% aa sequence identity. B7-H1/PD-L1 is one of two ligands for programmed death-1 (PD-1), a member of the CD28 family of immunoreceptors. The other identified ligand is PD-L2. Mouse B7-H1/PD-L1 and PD-L2 share approximately 34% aa sequence identity and have similar functions. B7-H1/PD-L1 is constitutively expressed in various lymphoid and non-lymphoid organs including placenta, heart, pancreas, lung, liver, and endothelium
(1‑4). The expression of B7-H1/PD-L1 is detected on B cells, T cells, monocytes, dendritic cells and thymic epithelial cells. IFN-gamma treatment induces B7-H1/PD-L1 expression in monocytes, dendritic cells, and endothelial cells. B7-H1/PD-L1 expression is also upregulated in a variety of tumor cell lines. On previously activated T cells, B7-H1/PD-L1 interaction with PD-1 inhibits TCR-mediated proliferation and cytokine production, suggesting an inhibitory role in regulating immune responses. In contrast, a costimulatory function for the PD-1 ligands on resting T cells has also beenreported (1-4).
References
- Tamura, H. et al. (2001) Blood 97:1809.
- Freeman, G. et al. (2000) J. Exp. Med. 192:1027.
- Sharpe, A.H. and G. J. Freeman (2002) Nat. Rev. Immunol. 2:116.
- Coyle, A. and J. Gutierrez-Ramos (2001) Nat. Immunol. 2:203.
Long Name
Alternate Names
Entrez Gene IDs
Gene Symbol
UniProt
Additional PD-L1/B7-H1 Products
Product Documents for Mouse PD-L1/B7-H1 Antibody
Product Specific Notices for Mouse PD-L1/B7-H1 Antibody
For research use only